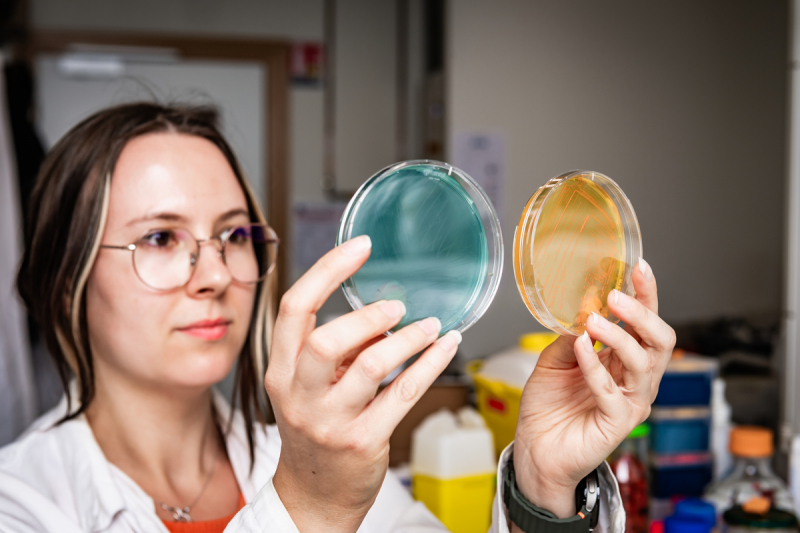
Une femme isole sur une boîte de Petri une souche bactérienne capable de dégrader un composé fluoré

Qu’est-ce que l’interdisciplinarité change aux métiers de la recherche ?
Depuis de nombreuses années, l’interdisciplinarité s’est imposée comme une valeur et une pratique centrale de la recherche scientifique. Mais comment construit-on concrètement un tel dialogue entre les disciplines ?
Cet article est le deuxième d’une série de cinq sur le futur de la recherche.
Changement climatique, transition numérique, crises sanitaires… Les grands défis de notre époque sont particulièrement complexes : ils poussent ainsi les scientifiques à croiser leurs regards et leurs expertises. « Désormais, les disciplines s’entremêlent : nous avons atteint aujourd’hui un niveau de connaissances fondamentales qui déborde le simple cadre disciplinaire », constate Stefania Rosolen, doctorante au CNRS1 et à l’Office for Climate Education2 . L’interdisciplinarité s’impose peu à peu comme une alternative nécessaire pour aborder ces questions de recherche, à l’interface entre science et société. « Il y a derrière ces recherches interdisciplinaires l’idée de répondre à toute une série de problèmes qui touchent nos sociétés, souvent diagnostiqués comme étant urgents, et qui nécessitent d’aller au-delà du découpage disciplinaire classique », observe Wolf Feuerhahn, historien des sciences et des savoirs au CNRS3 . « Le fait de rassembler des regards différents et que plusieurs chercheurs et chercheuses issus de disciplines variées travaillent ensemble permet de faire émerger des approches scientifiques originales », complète Martina Knoop, directrice de la Mission pour les initiatives transverses et interdisciplinaires (Miti) du CNRS.
« L’interdisciplinarité nous amène ainsi à explorer des espaces inconnus », se réjouit François Parcy, directeur de recherche au CNRS en biologie végétale4 . Le chercheur grenoblois a présidé durant quatre ans la Commission interdisciplinaire 51 (CID 51) : « Modélisation mathématique, informatique et physique pour les sciences du vivant ». « Notre rôle au sein de la CID 51 consiste principalement à recruter des scientifiques qui vont mener des recherches interdisciplinaires dans les laboratoires du CNRS », précise François Parcy. En créant des interactions entre différentes disciplines, « nous pouvons aborder de grandes questions liées à la biologie que les spécialistes de cette thématique n’arrivent pas à traiter seuls. L’intérêt est d’utiliser un formalisme issu de l’informatique, de la physique ou des mathématiques pour étudier ces questions », ajoute le biologiste. Et dans le même temps, les sciences les plus formelles peuvent se nourrir de la biologie : « Les réseaux de neurones, très fréquemment utilisés en informatique, sont par exemple directement inspirés du vivant », note François Parcy.
- 1Au laboratoire Locean (CNRS / IRD / MNHN / Sorbonne Université).
- 2L Office for Climate Education vise à promouvoir l éducation au changement climatique auprès des enseignants du monde entier et à fournir ainsi à leurs élèves les outils nécessaires pour comprendre et agir sur le changement climatique.
- 3Au sein du Centre Alexandre-Koyré (CNRS / EHESS / MNHN).
- 4Au sein du Laboratoire de physiologie cellulaire et végétale (CEA / CNRS / Inrae / Université Grenoble-Alpes).
L’interdisciplinarité permet également de bousculer les cadres établis, observe Wolf Feuerhahn : « Même si ces recherches ne sont pas forcément vouées au succès, elles permettent d’aborder les questions de manière plus riche, en faisant un pas de côté par rapport aux cadres intellectuels préconçus ». « Il m’est par exemple arrivé d’imaginer qu’un problème biologique était résolu et serait facile à modéliser, puis de constater, après avoir échangé avec un mathématicien que le modèle ne fonctionnait pas du tout, ajoute François Parcy. Cela a permis de mettre en évidence des manques dans la compréhension du sujet que je ne pouvais pas voir seul ».
Explorer des espaces inconnus
Néanmoins, ce dialogue entre différentes disciplines scientifiques est rarement spontané. « Pour développer l’interdisciplinarité, il faut imaginer des espaces où l’objet d’étude prime sur le cadre disciplinaire », souligne Wolf Feuerhahn. Sous l’impulsion de la Miti, créée en 2011, des groupements de recherche (GDR) ont ainsi vu le jour. C’est notamment le cas du GDR Océan et mers (Omer), consacré aux milieux océaniques et marins. « Certains de mes collègues font de l’océanographie, de la climatologie, de la physique, de la chimie ou de la biologie. D’autres sont spécialisés en paléoclimatologie, en histoire, en anthropologie ou encore en philosophie », détaille Stefania Rosolen, membre du GDR Omer et dont la thèse porte sur l’étude des savoirs liés au changement climatique et à l’océan dans les manuels scolaires. « Mes échanges avec d’autres chercheurs et chercheuses dans le cadre des groupes de travail, des séminaires et des colloques organisés par le GDR me permettent de découvrir des approches totalement différentes de celles que j’avais imaginées en amont de ma thèse », précise la doctorante. Et si toutes les disciplines peuvent travailler ensemble, « il est vrai qu’il est plus facile d’établir des ponts entre elles lorsque qu’elles sont plus proches, notamment au niveau des savoirs et des compétences exigés », assure Stefania Rosolen.
Ces cinq dernières années, la Miti a également effectué un important travail afin de mettre en avant le sujet des composés per- et polyfluoroalkylés, plus connus sous le nom de « PFAS ». Ces substances, surnommées « polluants éternels » en raison de leur persistance dans l’environnement, préoccupent la communauté scientifique. « Ils ont été largement utilisés en raison de leurs propriétés extraordinaires, mais depuis plusieurs années on a constaté leurs effets néfastes sur l’environnement et sur notre santé, précise Martina Knoop. Nous avons donc organisé des colloques et des appels à projets afin de mettre en lien les scientifiques mais aussi les acteurs de la société et les industriels qui travaillent sur cette question ». Les enjeux sont nombreux : il s’agit notamment de réussir à trouver des substituts aux PFAS ou encore de parvenir à développer des stratégies d’analyse et de dépollution. Pour cela, il est nécessaire « d’aller au-delà du périmètre académique », souligne Martina Knoop. Afin de mener à bien cette mission sur les PFAS, la Miti s’est associée à la direction des relations avec les entreprises du CNRS. Cette dernière est chargée de développer et de renforcer les collaborations de recherche entre les acteurs des filières industrielles et économiques et les laboratoires sous tutelle CNRS.
Construire des espaces de dialogue
Cependant, le défi principal reste de parvenir à pérenniser ce dialogue entre différentes disciplines au cours du temps. Avant tout, il est indispensable qu’aucune matière ne prenne le pas sur les autres, souligne Martina Knoop : « Les questions de recherche ne doivent pas devenir des notions de service. Il faut absolument éviter d’avoir une vision hiérarchique des disciplines ». Le fait de co-construire un projet interdisciplinaire prend également nécessairement plus de temps qu’un projet disciplinaire, concède Martina Knoop : « Il faut notamment s’accorder sur le vocabulaire, ainsi que sur la méthode et sur les hypothèses de travail ». Pour mettre en place ce type de projet, « il est nécessaire d’apprendre à se parler et à connaître le langage de l’autre. Ce n’est pas un processus dans lequel des mathématiciens vont par exemple se mettre au service des biologistes, ou inversement, complète François Parcy. Mais la capacité à se parler, à comprendre les problématiques des disciplines avec lesquelles on collabore et à créer des passerelles entre elles demande un tel investissement que cela fait indéniablement émerger de nouvelles compétences qui sont très précieuses dans le monde de la recherche ».
Néanmoins, ce temps consacré aux projets interdisciplinaires peut-il ralentir l’avancement des carrières dans la recherche ? « Pour le savoir, nous avons lancé une grande enquête en 2022 auprès des chercheurs et chercheuses du CNRS qui sont impliqués dans ce type de projet, précise Marylin Vantard, directrice de recherche émérite au CNRS et chargée de mission au sein de la Miti de 2021 à 2025. Les équipes de la mission ont notamment ciblé un critère en particulier : l’âge auquel les chercheurs et les chercheuses accèdent au statut de directeur ou directrice de recherche de classe 2. Résultat : « Sur près de 1000 répondants, nous n’avons pas observé de différences significatives dans l’avancement des carrières entre les scientifiques impliqués dans des projets interdisciplinaires et les autres », souligne Marylin Vantard. L’enquête montre la même chose concernant l’âge moyen d’entrée au CNRS : l’implication dans des projets interdisciplinaires durant une thèse ou un post-doctorat ne semble pas être un frein dans la carrière des jeunes scientifiques.
L’interdisciplinarité, frein aux carrières scientifiques ?
Pourtant, près de 4 personnes sur 10 interrogées dans cette enquête estiment que le fait de développer l’interdisciplinarité ralentit leur carrière. « Il faut signaler qu’il subsiste une insatisfaction autour de l’évaluation qui est faite des recherches interdisciplinaires : 64 % des répondants considèrent qu’elle n’est pas adaptée. Il est donc nécessaire de progresser sur ce point », poursuit Marylin Vantard. Les co-autrices de cette enquête menée par la Miti mettent ainsi en avant le besoin « d’engager la communauté scientifique plus en avant pour définir de nouveaux critères d’évaluation à ajouter ou à substituer à ceux utilisés pour l’évaluation des projets disciplinaires, ce qui demandera une plus grande sensibilisation et formation des évaluateurs ». « Je pense qu’il nous faut mieux cerner les spécificités liées à l’interdisciplinarité afin de pouvoir profiter pleinement de ce qu’elle peut nous apporter en tant que champ de recherche », confirme Stefania Rosolen.
« Les postes de titulaires académiques restent disciplinaires, souligne Wolf Feuerhahn. Tout le paradoxe réside dans le fait qu’il est nécessaire de faire œuvre d’interdisciplinarité pour saisir des problèmes très complexes, mais dans le même temps, les jeunes chercheurs et chercheuses doivent d’abord montrer qu’ils maîtrisent avant tout les savoirs et les compétences propres à chaque discipline ». « Au CNRS, près de 20 % des recrues ont des profils interdisciplinaires. Mais la situation dans les universités est différente. On constate que les profils interdisciplinaires ont des difficultés d’accès aux postes d’enseignants-chercheurs », observe Martina Knoop. La structuration par disciplines demeure ainsi un référentiel structurant dans le monde de la recherche : « Nous sommes encore loin d’avoir basculé dans un monde post-disciplinaire », conclut Wolf Feuerhahn.